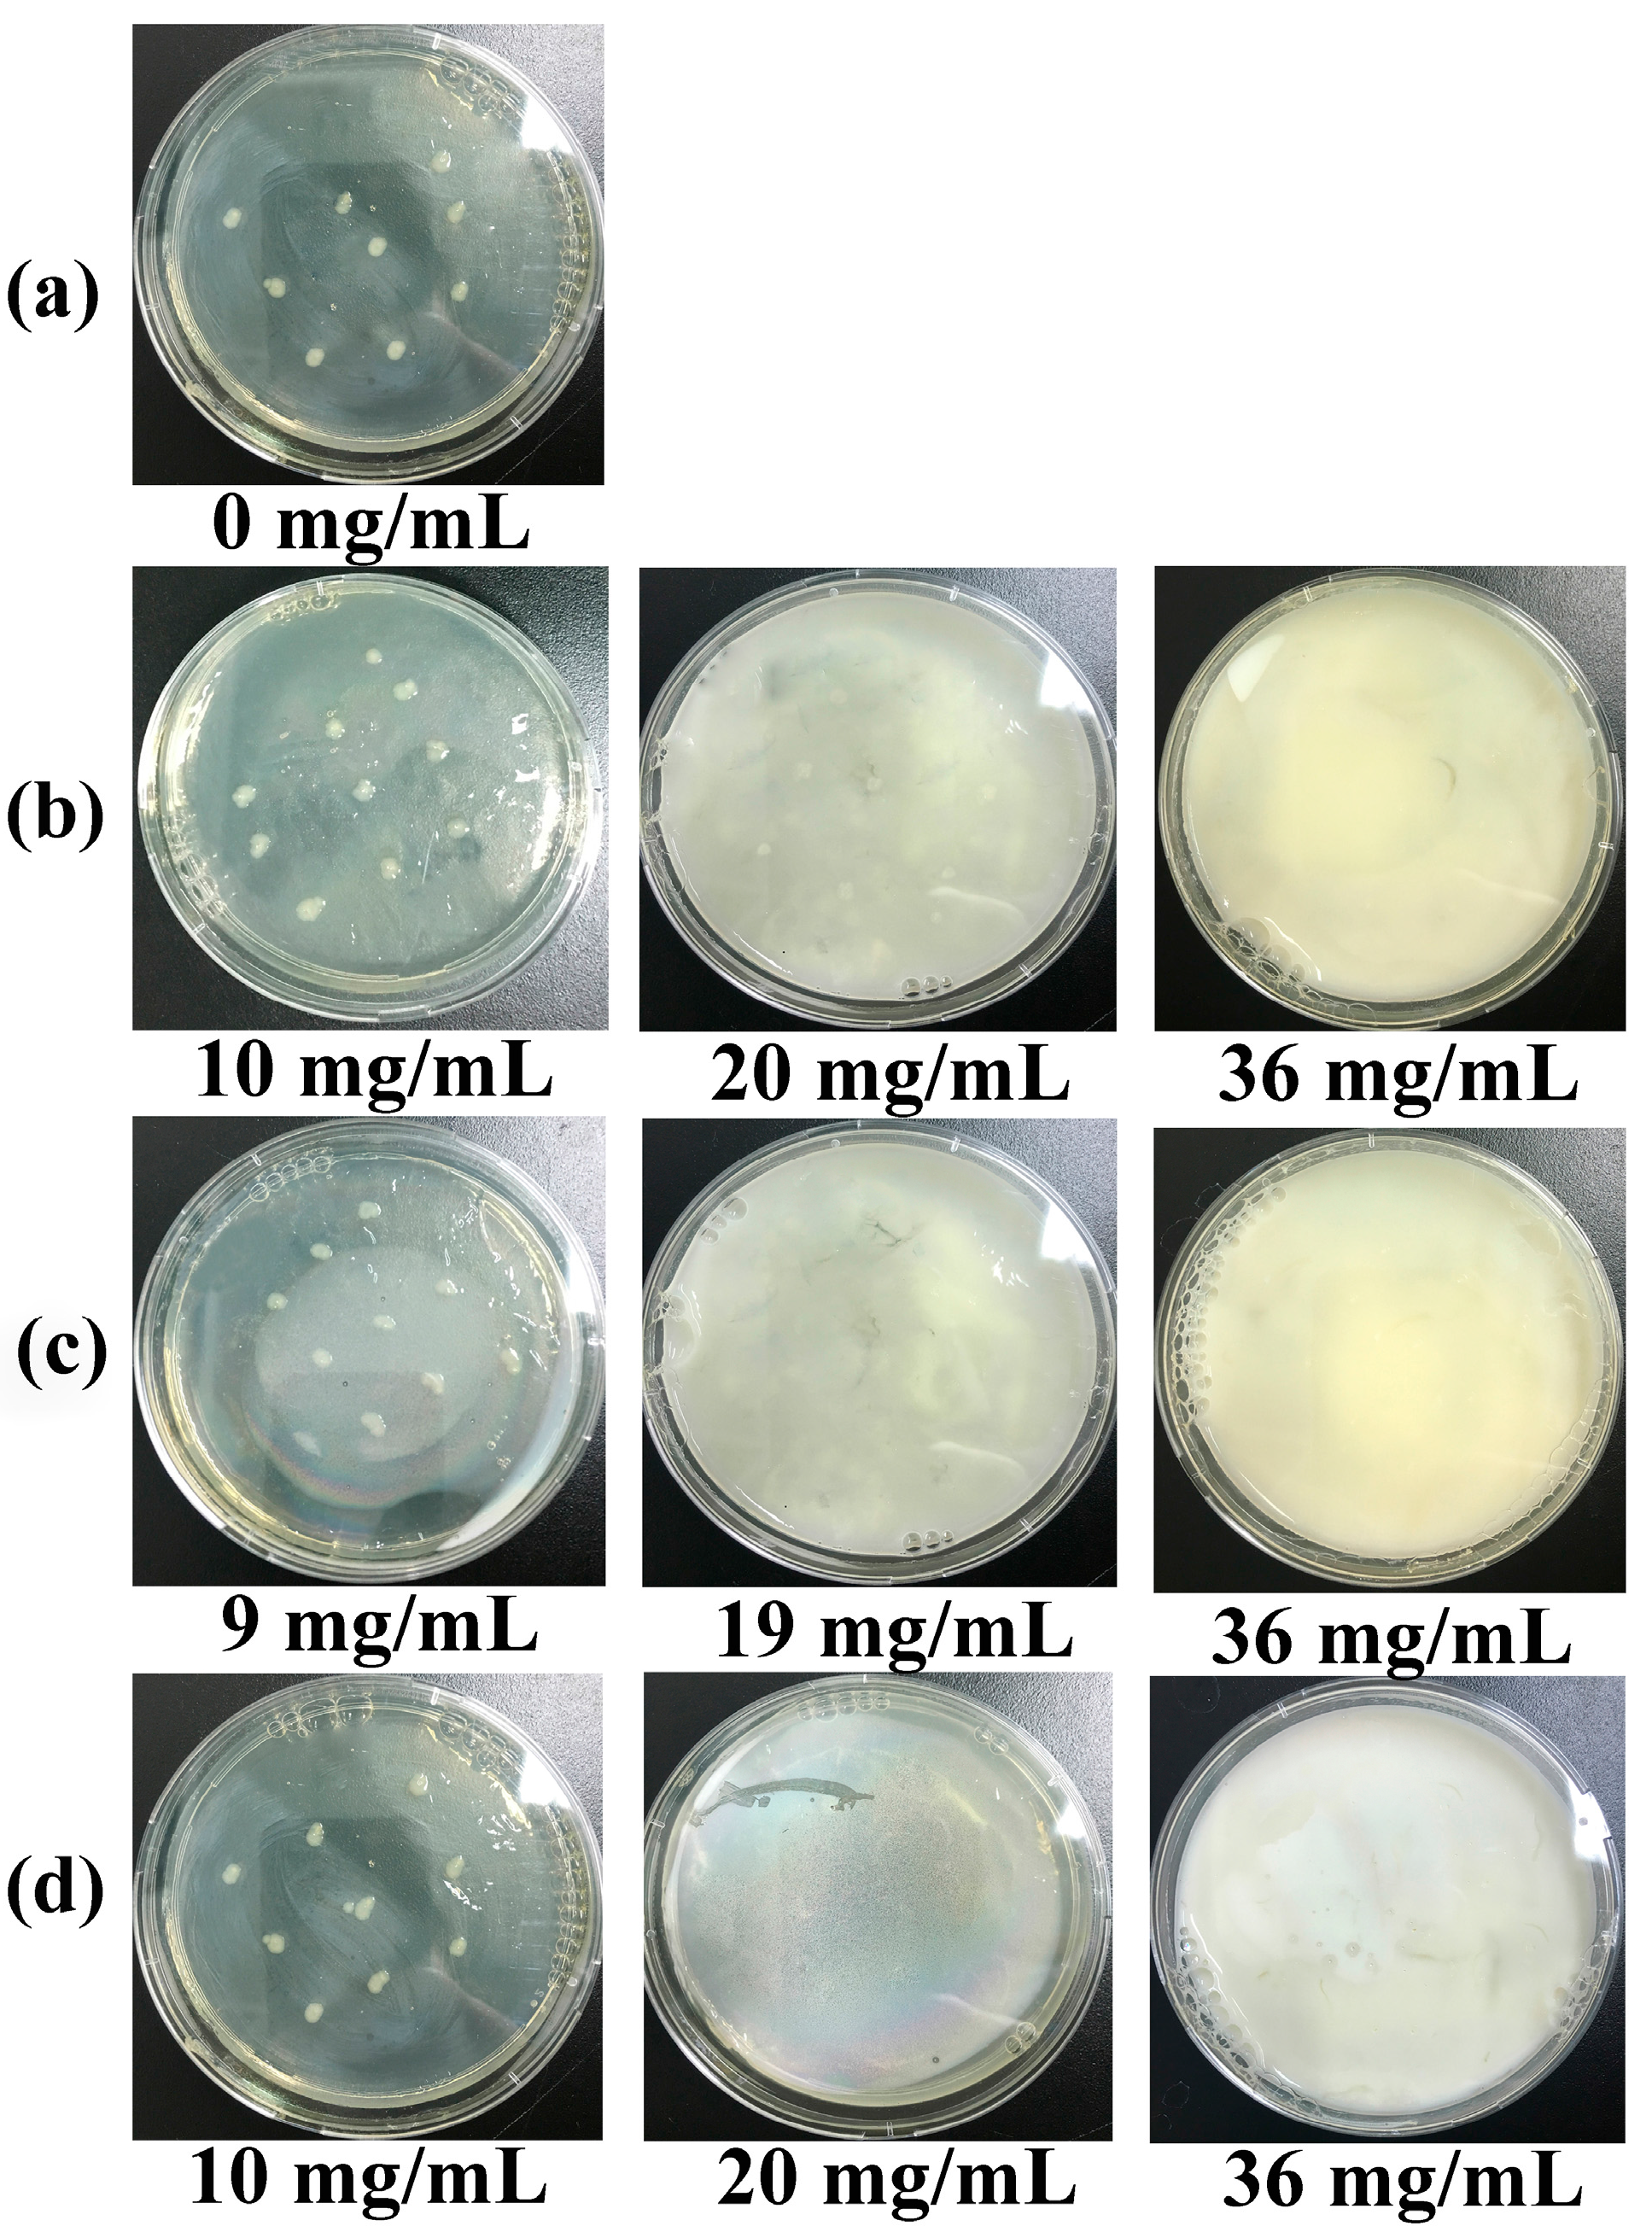

Preparation and Characterization of ZnO Nanoparticles Supported on Amorphous SiO2
Abstract
:1. Introduction
2. Experimental Procedure
2.1. Materials
2.2. ZnO–SiO2 Precursor
2.3. Preparation of ZnO–SiO2
2.4. Characterization
2.5. Antimicrobial Test
3. Results and Discussion
3.1. Structure and Characterization of ZnO–SiO2
3.1.1. Phase and Chemical Constitution of ZnO–SiO2
3.1.2. Microstructure of ZnO–SiO2
3.1.3. Formation Mechanism of ZnO–SiO2
3.2. Antibacterial Properties of ZnO–SiO2
4. Conclusions
Acknowledgments
Author Contributions
Conflicts of Interest
References
- Ficociello, G.; Zanni, E.; Cialfi, S.; Aurizi, C.; Biolcati, G.; Palleschi, C.; Talora, C.; Uccelletti, D. Glutathione S-transferase θ-subunit as a phenotypic suppressor of pmr1Δ strain, the Kluyveromyces lactis model for Hailey-Hailey disease. Biochim. Biophys. Acta 2016, 1863, 2650–2657. [Google Scholar] [CrossRef] [PubMed]
- Zanni, E.; Laudenzi, C.; Schifano, E.; Palleschi, C.; Perozzi, G.; Uccelletti, D.; Devirgiliis, C. Impact of a Complex Food Microbiota on Energy Metabolism in the Model Organism Caenorhabditis elegans. BioMed Res. Int. 2015, 2015, 621709. [Google Scholar] [CrossRef] [PubMed]
- Uccelletti, D.; Zanni, E.; Guerisoli, M.; Palleschi, C. Caenorhabditis elegans: an emerging animal model for biomonitoring environmental toxicity. J. Biotechnol. 2010, 150, 257. [Google Scholar] [CrossRef]
- Malachová, K.; Praus, P.; Rybková, Z.; Kozák, O. Antibacterial and antifungal activities of silver, copper and zinc montmorillonites. Appl. Clay Sci. 2011, 53, 642–645. [Google Scholar] [CrossRef]
- Zanni, E.; Chandraiahgari, C.R.; Bellis, G.D.; Montereali, M.R.; Armiento, G.; Ballirano, P.; Polimeni, A.; Sarto, M.S.; Uccelletti, D. Zinc Oxide Nanorods-Decorated Graphene Nanoplatelets: A Promising Antimicrobial Agent against the Cariogenic Bacterium Streptococcus mutans. Nanomaterials 2016, 6, 179. [Google Scholar] [CrossRef] [PubMed]
- Li, Y.; Zhang, W.; Niu, J.; Chen, Y. Mechanism of Photogenerated Reactive Oxygen Species and Correlation with the Antibacterial Properties of Engineered Metal-Oxide Nanoparticles. ACS Nano 2012, 6, 5164–5173. [Google Scholar] [CrossRef] [PubMed]
- Cha, S.H.; Hong, J.; Mcguffie, M.; Yeom, B.; Vanepps, J.S.; Kotov, N.A. Shape-Dependent Biomimetic Inhibition of Enzyme by Nanoparticles and Their Antibacterial Activity. ACS Nano 2015, 9, 9097–9105. [Google Scholar] [CrossRef] [PubMed]
- Vincenzini, P. Ceramic Powders; Elsevier Scientific Pub. Co: New York, NY, USA, 1983; Volume 16, pp. 843–849. [Google Scholar]
- Wang, M.-H.; Ma, X.-Y.; Jiang, W.; Zhou, F. Synthesis of doped ZnO nanopowders in alcohol–water solvent for varistors applications. Mater. Lett. 2014, 121, 149–151. [Google Scholar] [CrossRef]
- Chen, Y.; Kim, M.; Lian, G.; Johnson, M.B.; Peng, X. Side reactions in controlling the quality, yield, and stability of high quality colloidal nanocrystals. J. Am. Chem. Soc. 2005, 127, 13331–13337. [Google Scholar] [CrossRef] [PubMed]
- Pacholski, C.; Kornowski, A.; Weller, H. Self-Assembly of ZnO: From Nanodots to Nanorods. Angew. Chem. Int. Ed. 2002, 41, 1188–1191. [Google Scholar] [CrossRef]
- Choi, S.H.; Kim, E.G.; Park, J.; An, K.; Lee, N.; And, S.C.K.; Hyeon, T. Large-Scale Synthesis of Hexagonal Pyramid-Shaped ZnO Nanocrystals from Thermolysis of Zn-Oleate Complex. J. Phys. Chem. B 2005, 109, 14792–14794. [Google Scholar] [CrossRef] [PubMed]
- Pacholski, C.; Kornowski, A.; Weller, H. ZnO nanorods: Growth mechanism and anisotropic functionalization. In Proceedings of the SPIE 49th Annual Meeting on Optical Science and Technology, Denver, CO, USA, 2–6 August 2004. [Google Scholar]
- Ito, M.; Fukahori, S.; Fujiwara, T. Adsorptive removal and photocatalytic decomposition of sulfamethazine in secondary effluent using TiO2-zeolite composites. Environ. Sci. Pollut. Res. Int. 2014, 21, 834–842. [Google Scholar] [CrossRef] [PubMed]
- Hassani, A.; Khataee, A.; Karaca, S.; Karaca, C.; Gholami, P. Sonocatalytic degradation of ciprofloxacin using synthesized TiO2 nanoparticles on montmorillonite. Ultrason. Sonochem. 2017, 35, 251–262. [Google Scholar] [CrossRef] [PubMed]
- Xu, K.; Sun, Q.; Guo, Y.; Zhang, Y.; Dong, S. Preparation of super-hydrophobic white carbon black from nano-rice husk ash. Res. Chem. Intermed. 2013, 40, 1965–1973. [Google Scholar] [CrossRef]
- Chen, Y.; Peng, Z.; Kong, L.X.; Huang, M.F.; Li, P.W. Natural rubber nanocomposite reinforced with nano silica. Polym. Eng. Sci. 2008, 48, 1674–1677. [Google Scholar] [CrossRef]
- Khorsand Zak, A.; Majid, W.H.A.; Ebrahimizadeh Abrishami, M.; Yousefi, R.; Parvizi, R. Synthesis, magnetic properties and X-ray analysis of Zn0.97X0.03O nanoparticles (X = Mn, Ni, and Co) using Scherrer and size-strain plot methods. Solid State Sci. 2012, 14, 488–494. [Google Scholar] [CrossRef]
- Jones, N.; Ray, B.; Ranjit, K.T.; Manna, A.C. Antibacterial activity of ZnO nanoparticle suspensions on a broad spectrum of microorganisms. FEMS Microbiol. Lett. 2008, 279, 71–76. [Google Scholar] [CrossRef] [PubMed]
- Tam, K.H.; Djurišić, A.B.; Chan, C.M.N.; Xi, Y.Y.; Tse, C.W.; Leung, Y.H.; Chan, W.K.; Leung, F.C.C.; Au, D.W.T. Antibacterial activity of ZnO nanorods prepared by a hydrothermal method. Thin Solid Films 2008, 516, 6167–6174. [Google Scholar] [CrossRef]
- Zhong, Z.; Zhe, X.; Sheng, T.; Yao, J.; Xing, W.; Yong, W. Unusual Air Filters with Ultrahigh Efficiency and Antibacterial Functionality Enabled by ZnO Nanorods. ACS App. Mater. Interfaces 2015, 7, 21538–21544. [Google Scholar] [CrossRef] [PubMed]
- Schwalbe, R.; Steele-Moore, L.; Goodwin, A.C. Antimicrobial Susceptibility Testing Protocols; CRC Press: Boca Raton, FL, USA, 2007. [Google Scholar]
- Test Method and Effect for Antibacterial Capability of Paints Film. Available online: http://c.gb688.cn/bzgk/gb/showGb?type=online&hcno=BD23209B12F6B07650FD542B0EB1456A (accessed on 1 October 2008).
- Zuo, Z.; Liao, R.; Zhao, X.; Song, X.; Qiao, Z.; Guo, C.; Zhuang, A.; Yuan, Y. Anti-frosting performance of superhydrophobic surface with ZnO nanorods. Appl. Therm. Eng. 2017, 110, 39–48. [Google Scholar] [CrossRef]
- Perillo, P.M.; Atia, M.N.; Rodríguez, D.F. Effect of the reaction conditions on the formation of the ZnO nanostructures. Phys. E Low-Dimens. Syst. Nanostruct. 2017, 85, 185–192. [Google Scholar] [CrossRef]
- Al-Gaashani, R.; Radiman, S.; Daud, A.R.; Tabet, N.; Al-Douri, Y. XPS and optical studies of different morphologies of ZnO nanostructures prepared by microwave methods. Ceram. Int. 2013, 39, 2283–2292. [Google Scholar] [CrossRef]
- Gallegos, M.V.; Peluso, M.A.; Thomas, H.; Damonte, L.C.; Sambeth, J.E. Structural and optical properties of ZnO and manganese-doped ZnO. J. Alloys Compd. 2016, 689, 416–424. [Google Scholar] [CrossRef]
- Gao, H.; Song, Z.; Yang, L.; Wu, H. Synthesis Method of White Carbon Black Utilizing Water-Quenching Blast Furnace Slag. Energy Fuels 2016, 30, 9645–9651. [Google Scholar] [CrossRef]
- Ghotbi, M.Y. Synthesis and characterization of nano-sized ε-Zn(OH)2 and its decomposed product, nano-zinc oxide. J. Alloys Compd. 2010, 491, 420–422. [Google Scholar] [CrossRef]
- Hubert, C.; Naghavi, N.; Canava, B.; Etcheberry, A. Zinc Sulfide Based Chemically Deposited Buffer Layers for Electrodeposited CIS Solar Cells. In Proceedings of the Conference Record of the 2006 IEEE 4th World Conference on Photovoltaic Energy Conversion, Waikoloa, HI, USA, 7–12 May 2006. [Google Scholar]
- Nie, H.; He, A.; Zheng, J.; Xu, S.; Li, J.; Han, C.C. Effects of Chain Conformation and Entanglement on the Electrospinning of Pure Alginate. Biomacromolecules 2008, 9, 1362–1365. [Google Scholar] [CrossRef] [PubMed]
- Tai, Y.; Qian, J.; Zhang, Y.; Huang, J. Study of surface modification of nano-SiO2 with macromolecular coupling agent (LMPB-g-MAH). Chem. Eng. J. 2008, 141, 354–361. [Google Scholar] [CrossRef]

| Samples | SiO2/% | ZnO/% | Na2O/% |
|---|---|---|---|
| amorphous SiO2 | 96.63 | 0 | 0.98 |
| ZnO–SiO2-pH5.0 | 92.78 | 4.51 | 1.05 |
| ZnO–SiO2-pH7.0 | 84.22 | 11.26 | 2.68 |
| Samples | C1s (%) | Zn2p (%) | Si2p (%) | O1s (%) | O/Si |
|---|---|---|---|---|---|
| Amorphous SiO2 | 2.74 | 0 | 31.27 | 65.84 | 2.11 |
| Zn–SiO2-pH5.0 | 6.18 | 2.24 | 27.55 | 62.04 | 2.25 |
| ZnO–SiO2-pH5.0 | 3.48 | 2.47 | 30.03 | 63.68 | 2.12 |
| Zn–SiO2-pH7.0 | 6.90 | 6.24 | 24.38 | 60.84 | 2.50 |
| ZnO–SiO2-pH7.0 | 5.96 | 10.55 | 25.18 | 58.39 | 2.31 |
| MIC (mg/mL) | ZnO–SiO2-pH5.0 | ZnO–SiO2-pH7.0 | ZnO |
|---|---|---|---|
| E. coli | 36 | 19 | 20 |
| E. coli (ZnO) | 1.60 | 2.14 | 20 |
© 2017 by the authors. Licensee MDPI, Basel, Switzerland. This article is an open access article distributed under the terms and conditions of the Creative Commons Attribution (CC BY) license (http://creativecommons.org/licenses/by/4.0/).
Share and Cite
Chen, Y.; Ding, H.; Sun, S. Preparation and Characterization of ZnO Nanoparticles Supported on Amorphous SiO2. Nanomaterials 2017, 7, 217. https://doi.org/10.3390/nano7080217
Chen Y, Ding H, Sun S. Preparation and Characterization of ZnO Nanoparticles Supported on Amorphous SiO2. Nanomaterials. 2017; 7(8):217. https://doi.org/10.3390/nano7080217
Chicago/Turabian StyleChen, Ying, Hao Ding, and Sijia Sun. 2017. "Preparation and Characterization of ZnO Nanoparticles Supported on Amorphous SiO2" Nanomaterials 7, no. 8: 217. https://doi.org/10.3390/nano7080217
APA StyleChen, Y., Ding, H., & Sun, S. (2017). Preparation and Characterization of ZnO Nanoparticles Supported on Amorphous SiO2. Nanomaterials, 7(8), 217. https://doi.org/10.3390/nano7080217
